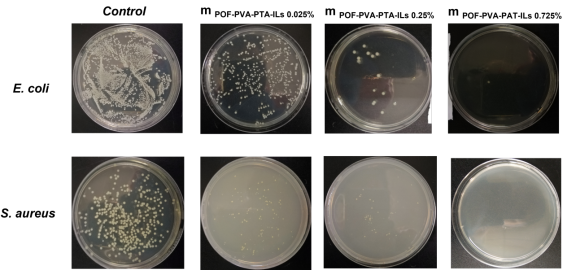

2024年5月—2025年6月,由必威西汉姆联范玲老师指导的广西民族大学创新创业训练项目“绿源盾——绿色可循环的离子凝胶柔性材料在电子传感器中的应用”项目顺利开展。项目成员梁霞、江美季、陆安松在扬帆楼318实验室完成了烯烃化聚乙烯醇-聚硫辛酸钠-胆碱离子液体(POF-PVA-PTA-ILs)离子凝胶的合成实验。
本项目从材料源头入手,以生物安全的聚乙烯醇、抗氧化剂硫辛酸和胆碱类离子液体为研究对象,构建具有3D 网络结构的POF-PVA-PTA-ILs离子凝胶基生物电子传感器,期望取得优良机械性能、柔韧性高和具备自修复性能的生物医学传感器。由于POF-PVA-PTA-ILs基离子凝胶是一类绿色可循环,生物安全性及具备自修复性能的电子皮肤材料,所以本项目实验以聚乙烯醇、硫辛酸和胆碱类离子液体为原料,合成具有高弹性的自修复性POF-PVA-PTA-ILs离子凝胶材料。通过反复地试验和不断地探索,解决了水凝胶易失传统水变硬和离子凝胶机械性能弱的问题。最终,实验结果表明,POF-PVA-PTA-ILs离子凝胶具有机械性能强,高弹性,生物安全性以及自修复性能好等优良性能,可广泛应用于柔性电子传感器行业中。
图1 不同离子液体含量的离子凝胶样品的抗菌性

图2 不同样品的表征:NIH3N3 fibroblasts

图3拉伸性能效果
(来源:必威西汉姆联 作者:梁霞 摄影:梁霞 编辑:赵青 初审:赵青 复审:刘前程 终审:黄钦)